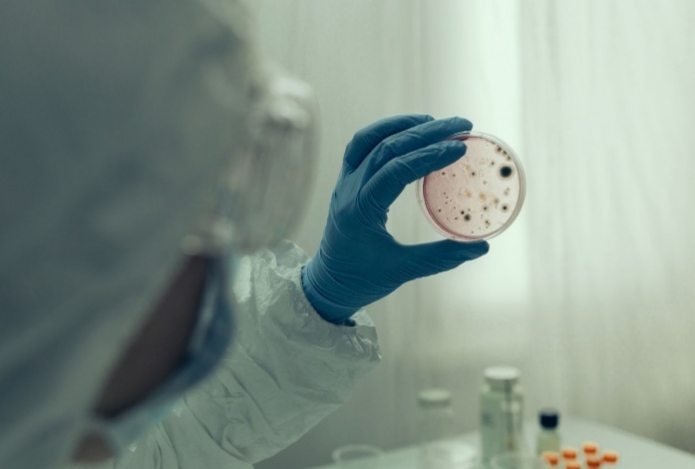
Канада призывала готовиться к новому опасному вирусу, который будет опаснее COVID-19

Канада призывала готовиться к новому опасному вирусу, который будет опаснее COVID-19
19 августа 2024, 00:19
Канадское правительство огорошило население заявлением о надвигающейся вирусной угрозе, передает Sports.kz со ссылкой на «Чемпионат».
Власти выпустили рекомендации, предупреждающие граждан о необходимости подготовиться к новому вирусу, который будет опаснее ковида, пишет Daily Mail.
В документе написано, что новый вирус может спровоцировать серьёзную вспышку заболеваемости и высокую смертность среди пожилых людей. Работодателям советуют быть готовыми к тому, что при новой пандемии люди вынуждены будут находиться на самоизоляции.
Будущая пандемия «пройдёт двумя или тремя волнами, каждая вспышка будет разделена на три-девять месяцев», отмечается в руководстве. Эксперты подчёркивают, что гипотетический вирус может сохраняться в этих циклах до двух лет.
Людей призывают подготовиться к сокращению цепочек поставок и изменению потребительского спроса. Возможны перебои в поставках бензина, медикаментов и продуктов питания.
Подписывайтесь на главные новости
казахстанского спорта в Telegram


Бразильский тренер рассказал, когда возглавит сборную Казахстана

Казахстанский боксер выдал бой года и получил признание. Видео

Махмуд Сабырхан уделал двух узбекистанцев и стал лучшим боксером года
